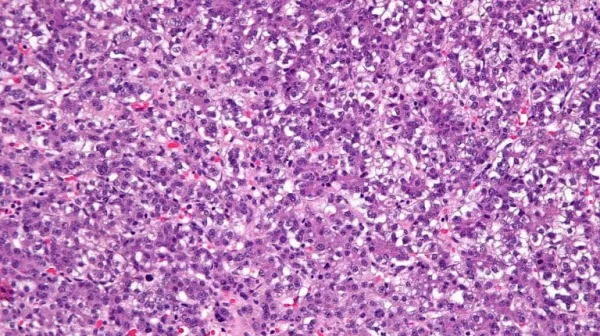

Pavel Sumazin, PhD
- Cancer and Blood Disorders

Director, Bioinformatics Core Laboratory, Cancer and Hematology Center
Professor, Department of Pediatrics, Division of Hematology-Oncology, Baylor College of Medicine
Departments:
Office location:
1102 Bates Avenue
Houston, TX 77030
Get to know Pavel Sumazin, PhD
Education
| School | Education | Degree | Year |
|---|---|---|---|
| Columbia University | Fellowship | Systems Biology | 2013 |
| Cold Spring Harbor Laboratory | Post-doctoral Fellowship | Human Genetics | 2005 |
| Stony Brook University | PhD | Doctor of Philosophy, Computer Science | 2002 |
* Texas Children’s Hospital physicians’ licenses and credentials are reviewed prior to practicing at any of our facilities. Sections titled From the Doctor, Professional Organizations and Publications were provided by the physician’s office and were not verified by Texas Children’s Hospital.
Highlights
Research Area:
Genetics and Genomics
Dr. Pavel Sumazin is Director of the Bioinformatics Core Laboratory and a member of the Cancer Genetics and Genomics Program and the Center for Precision Oncology at Texas Children's Cancer and Hematology Center. He is also a member of the Quantitative and Computational Biosciences Department, Therapeutic Innovation Center, and Dan L Duncan Comprehensive Cancer Center at Baylor College of Medicine.
Dr. Sumazin studies cancer systems biology, including technology development and its applications to cancer genomics. He has contributed to comparative studies of cancers, studies of non-coding RNAs in cancer, and the design of diagnostic algorithms to optimize therapies for cancer patients. He helped design biochemical and computational technologies to resolve the composition and phylogeny of cancers, and he helped identify cancer clones that influence etiology, progression, and response to therapies.
Dr. Sumazin interprets molecular profiles of human tumors to inform cancer diagnostics and therapeutics. He aims to infer pathophysiological consequences of somatic and germline alterations by mapping out amplification and propagation pathways that channel their effects to alter the activity of cancer genes. Towards this goal, he has helped reverse-engineer transcriptional and post-transcriptional regulatory networks in multiple human cancers, identifying genes that regulate cell survival and proliferation, DNA damage response, and cancer progression. Specifically, Dr. Sumazin has helped identify a molecular signature to distinguish indolent from aggressive prostate cancer, a tumor suppressor tRNA-derived microRNA in B cell lymphoma, genes that target tumor-suppressors PTEN and RB1 through competition for microRNA regulation in glioblastoma, and transcription factors that regulate proliferation in germinal centers.